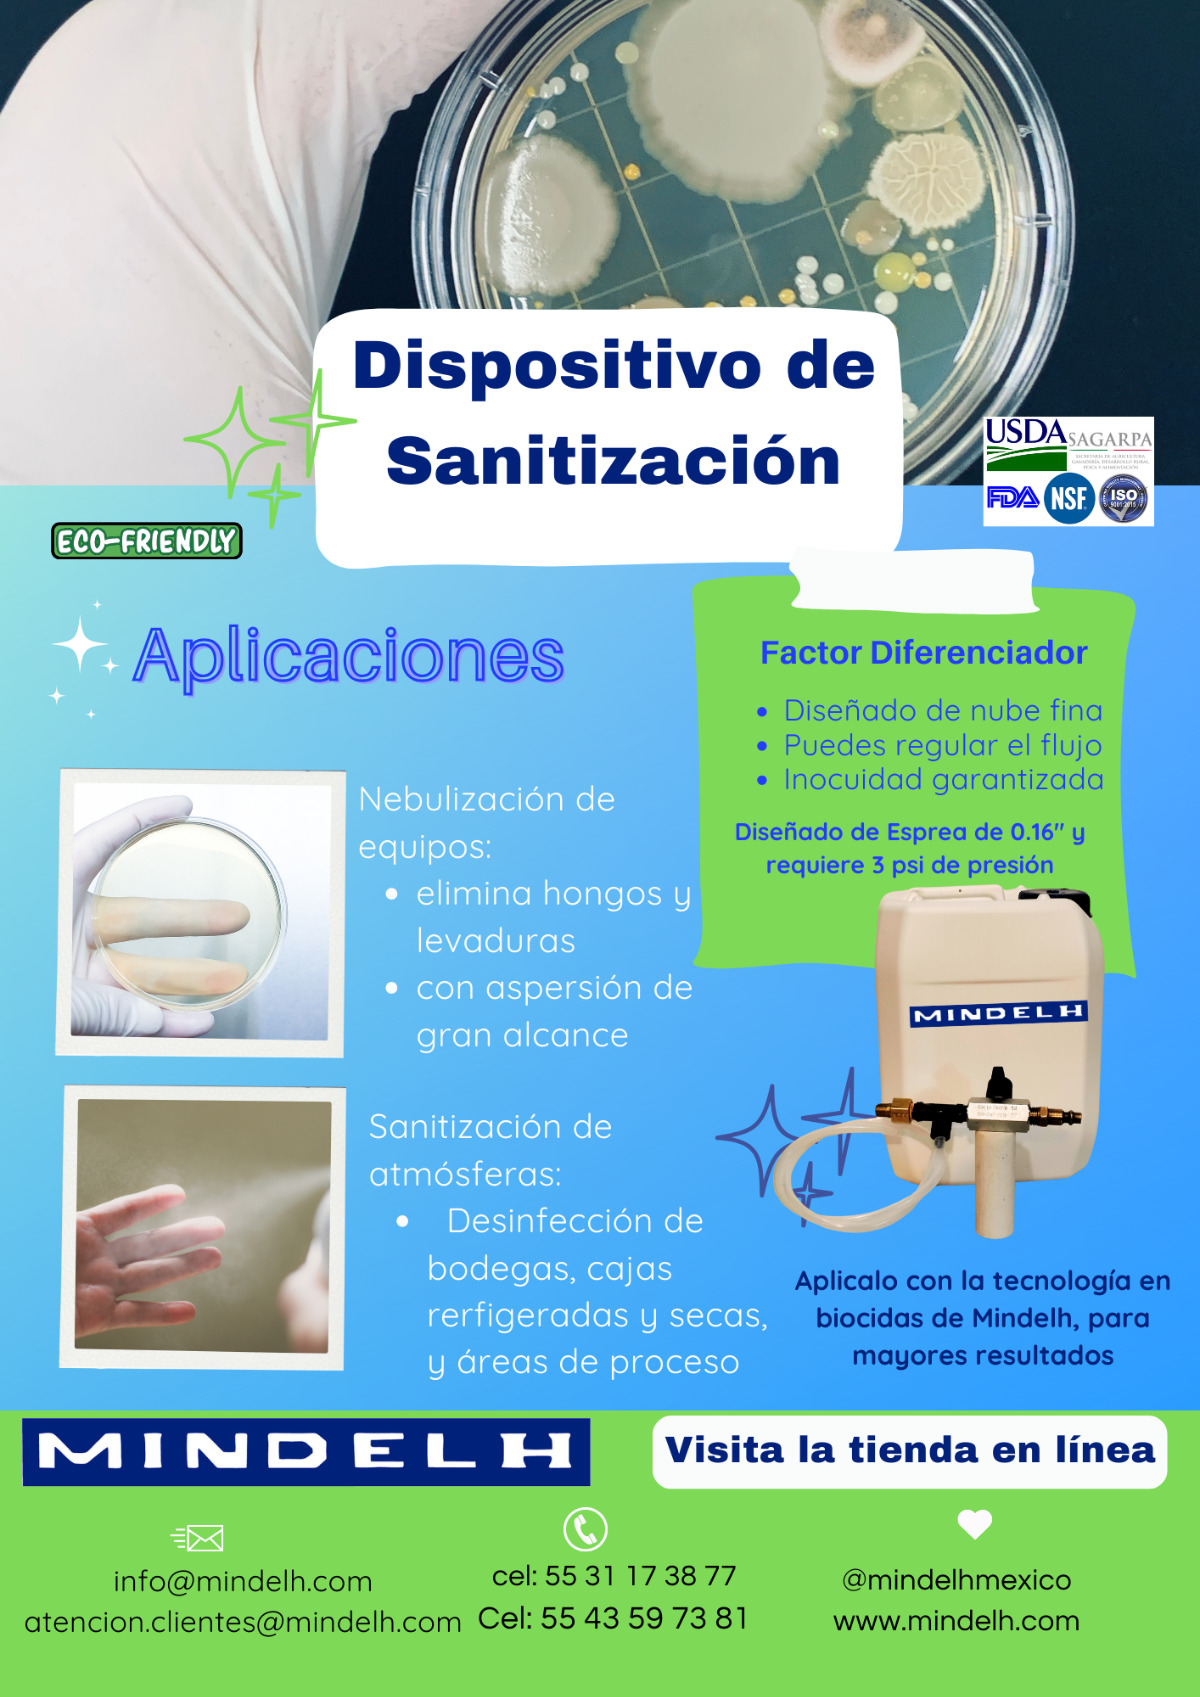
image

Hola, soy Marco Antonio (pero dime Marco)
Llevo 23 años asesorando en procesos de saneamiento de plantas alimenticias. Y no, no es glamoroso... hasta que descubres cómo hacerlo bien.
¿Por qué me escuchas a mí?
Porque pasé dos décadas viendo cómo las empresas gastan fortunas en sistemas de saneamiento que:
- Les complican la vida
- Les queman dinero en químicos que no necesitan
- Les hacen temer cada auditoría como si fuera el fin del mundo
Así que desarrollé un método diferente. Uno que funciona sin drama.
Cada 15 días te voy a mandar: Un email con algo útil. Nada de teoría aburrida. Solo tips que te ahorran tiempo, agua, electricidad y dolores de cabeza en sectores como alimentos, huevo procesado, agrícola, acuícola y HACCP.
Tu regalo de bienvenida (llega en 5 minutos): Tres calculadoras que todo profesional de inocuidad debería tener:
- Cómo cubicar un tanque (sin volverte loco)
- Dosificación en ppm (la forma fácil)
- Dosificación en % vol/vol (directo al punto)
Aviso de supervivencia digital:
El correo con tus calculadoras probablemente caiga en spam (siempre pasa la primera vez). Búscalo ahí y muévelo a tu bandeja principal. Así no nos perderemos.
Una cosa más:
Si enfrentas algún lío con auditorías, contaminación cruzada o químicos que no funcionan como prometían... responde cualquier email mío. He visto casi todo y si puedo ayudar, lo haré.
Nos leemos pronto,
Marco Antonio Roa
Dr. en Química Orgánica (pero la vida real me enseñó más que el doctorado)